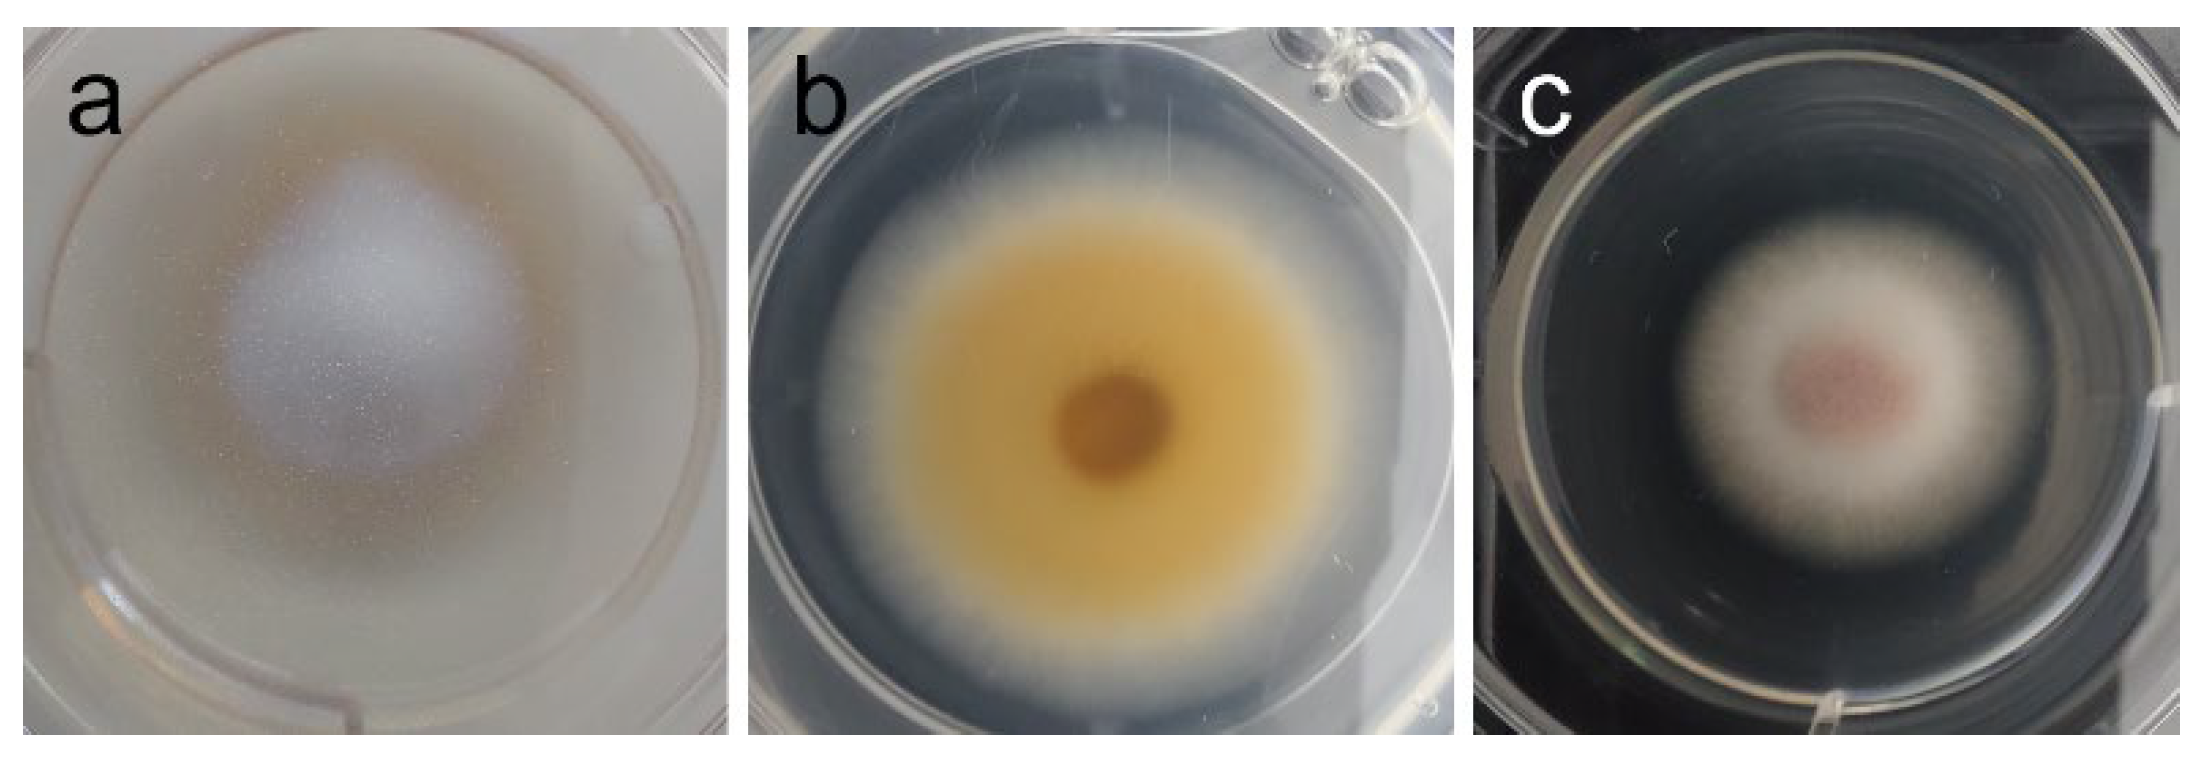
Ijms 26 11358 g006 Ijms 26 11358 g006

On the Antimicrobial Potential of Asparagopsis armata’s Ethanol Extract: A New Multiple-Industry Bio-Product?
Abstract
1. Introduction
2. Results
3. Discussion
4. Materials and Methods
4.1. Seaweed Biomass Harvesting and Processing
4.2. Ethanol Solid-Liquid Extraction
4.3. Extract Chemical Characterization (Gas Chromatography-Mass Spectrometry, GC-MS)
4.4. Extract’s Antioxidant Activity
4.4.1. Ferric Reducing Antioxidant Potential (FRAP)
4.4.2. Oxygen Radical Absorption Capacity (ORAC)
4.4.3. Lipid Peroxidation Inhibitory Potential (LPIP)
4.5. Extract’s Antimicrobial Activity
4.5.1. Antibacterial and Anti-Yeast Activity
4.5.2. Antifungal Activity (Filamentous Fungi)
4.6. Cell-Based Assays
Supplementary Materials
Author Contributions
Funding
Institutional Review Board Statement
Informed Consent Statement
Data Availability Statement
Acknowledgments
Conflicts of Interest
References
- Carroll, A.R.; Copp, B.R.; Davis, R.A.; Keyzers, R.A.; Prinsep, M.R. Marine Natural Products. Nat. Prod. Rep. 2021, 38, 362–413. [Google Scholar] [CrossRef] [PubMed]
- Pintéus, S.; Lemos, M.F.L.; Alves, C.; Neugebauer, A.; Silva, J.; Thomas, O.P.; Botana, L.M.; Gaspar, H.; Pedrosa, R. Marine Invasive Macroalgae: Turning a Real Threat into a Major Opportunity—The Biotechnological Potential of Sargassum muticum and Asparagopsis armata. Algal Res. 2018, 34, 217–234. [Google Scholar] [CrossRef]
- Ferreira, C.A.M.; Félix, R.; Félix, C.; Januário, A.P.; Alves, N.; Novais, S.C.; Dias, J.R.; Lemos, M.F.L. A Biorefinery Approach to the Biomass of the Seaweed Undaria pinnatifida (Harvey Suringar, 1873): Obtaining Phlorotannins-Enriched Extracts for Wound Healing. Biomolecules 2021, 11, 461. [Google Scholar] [CrossRef]
- Martins, G.M.; Cacabelos, E.; Faria, J.; Álvaro, N.; Prestes, A.C.L.; Neto, A.I. Patterns of Distribution of the Invasive Alga Asparagopsis armata Harvey: A Multi-Scaled Approach. Aquat. Invasions 2019, 14, 582–593. [Google Scholar] [CrossRef]
- Félix, R.; Dias, P.; Félix, C.; Cerqueira, T.; Andrade, P.B.; Valentão, P.; Lemos, M.F.L. The Biotechnological Potential of Asparagopsis armata: What Is Known of Its Chemical Composition, Bioactivities and Current Market? Algal Res. 2021, 60, 102534. [Google Scholar] [CrossRef]
- Félix, R.; Félix, C.; Januário, A.P.; Carmona, A.M.; Baptista, T.; Gonçalves, R.A.; Sendão, J.; Novais, S.C.; Lemos, M.F.L. Tailoring Shrimp Aquafeed to Tackle Acute Hepatopancreatic Necrosis Disease by Inclusion of Industry-Friendly Seaweed Extracts. Aquaculture 2020, 529, 735661. [Google Scholar] [CrossRef]
- Viant, M.R.; Kurland, I.J.; Jones, M.R.; Dunn, W.B. How Close Are We to Complete Annotation of Metabolomes? Curr. Opin. Chem. Biol. 2017, 36, 64–69. [Google Scholar] [CrossRef] [PubMed]
- Afonso, C.; Correia, A.P.; Freitas, M.V.; Mouga, T.; Baptista, T. In Vitro Evaluation of the Antibacterial and Antioxidant Activities of Extracts of Gracilaria gracilis with a View into Its Potential Use as an Additive in Fish Feed. Appl. Sci. 2021, 11, 6642. [Google Scholar] [CrossRef]
- Pinto, D.C.G.A.; Lesenfants, M.L.; Rosa, G.P.; Barreto, M.C.; Silva, A.M.S.; Seca, A.M.L. GC-and UHPLC-MS Profiles as a Tool to Valorize the Red Alga Asparagopsis armata. Appl. Sci. 2022, 12, 892. [Google Scholar] [CrossRef]
- Olsson, J.; Toth, G.B.; Albers, E. Biochemical Composition of Red, Green and Brown Seaweeds on the Swedish West Coast. J. Appl. Phycol. 2020, 32, 3305–3317. [Google Scholar] [CrossRef]
- Chan, P.T.; Matanjun, P. Chemical Composition and Physicochemical Properties of Tropical Red Seaweed, Gracilaria changii. Food Chem. 2017, 221, 302–310. [Google Scholar] [CrossRef] [PubMed]
- Gamero-Vega, G.; Palacios-Palacios, M.; Quitral, V. Nutritional Composition and Bioactive Compounds of Red Seaweed: A Mini-Review. J. Food Nutr. Res. 2020, 8, 431–440. [Google Scholar] [CrossRef]
- Freitas, M.V.; Inácio, L.G.; Martins, M.; Afonso, C.; Pereira, L.; Mouga, T. Primary Composition and Pigments of 11 Red Seaweed Species from the Center of Portugal. J. Mar. Sci. Eng. 2022, 10, 1168. [Google Scholar] [CrossRef]
- Leach, C.M. Ultraviolet-Absorbing Substances Associated with Light-Induced Sporulation in Fungi. Can. J. Bot. 1965, 43, 185–200. [Google Scholar] [CrossRef]
- Félix, R.; Santos, S.A.O.; Pais, A.C.S.; Rocha, S.M.; Silvestre, A.J.D. The Quest for Phenolic Compounds from Macroalgae: A Review of Extraction and Identification Methodologies. Biomolecules 2019, 9, 847. [Google Scholar] [CrossRef]
- Kramer, K.J.; Kagan, I.A.; Lawrence, L.M.; Smith, S.R. Ethanol-Soluble Carbohydrates of Cool-Season Grasses: Prediction of Concentration by Near-Infrared Reflectance Spectroscopy (NIRS) and Evaluation of Effects of Cultivar and Management. J. Equine Vet. Sci. 2021, 101, 103421. [Google Scholar] [CrossRef]
- Tiwari, P.; Kumar, B.; Mandeep, K.; Kaur, G.; Kaur, H. Phytochemical Screening and Extraction: A Review. Int. Pharm. Sci. 2011, 1, 98–106. [Google Scholar]
- Yang, F.; Xiang, W.; Sun, X.; Wu, H.; Li, T.; Long, L. A Novel Lipid Extraction Method from Wet Microalga Picochlorum Sp. at Room Temperature. Mar. Drugs 2014, 12, 1258–1270. [Google Scholar] [CrossRef]
- Caesar, J.; Tamm, A.; Ruckteschler, N.; Lena Leifke, A.; Weber, B. Revisiting Chlorophyll Extraction Methods in Biological Soil Crusts—Methodology for Determination of Chlorophyll a and Chlorophyll a + b as Compared to Previous Methods. Biogeosciences 2018, 15, 1415–1424. [Google Scholar] [CrossRef]
- Noviendri, D.; Jaswir, I.; Salleh, H.M.; Taher, M.; Miyashita, K.; Ramli, N. Fucoxanthin Extraction and Fatty Acid Analysis of Sargassum binderi and S. duplicatum. J. Med. Plants Res. 2011, 5, 2405–2412. [Google Scholar]
- Linser, A. Glycerine as Fungicide or Bactericide Active Substance; World Intellectual Property Organization: Geneva, Switzerland, 2002. [Google Scholar]
- Stout, E.I.; McKessor, A. Glycerin-Based Hydrogel for Infection Control. Adv. Wound Care 2012, 1, 48–51. [Google Scholar] [CrossRef] [PubMed]
- Nalawade, T.; Sogi, S.H.P.; Bhat, K. Bactericidal Activity of Propylene Glycol, Glycerine, Polyethylene Glycol 400, and Polyethylene Glycol 1000 against Selected Microorganisms. J. Int. Soc. Prev. Community Dent. 2015, 5, 114–119. [Google Scholar] [CrossRef] [PubMed]
- Saegeman, V.S.M.; Ectors, N.L.; Lismont, D.; Verduyckt, B.; Verhaegen, J. Short- and Long-Term Bacterial Inhibiting Effect of High Concentrations of Glycerol Used in the Preservation of Skin Allografts. Burns 2008, 34, 205–211. [Google Scholar] [CrossRef] [PubMed]
- Casillas-Vargas, G.; Ocasio-Malavé, C.; Medina, S.; Morales-Guzmán, C.; Del Valle, R.G.; Carballeira, N.M.; Sanabria-Ríos, D.J. Antibacterial Fatty Acids: An Update of Possible Mechanisms of Action and Implications in the Development of the next-Generation of Antibacterial Agents. Prog. Lipid Res. 2021, 82, 101093. [Google Scholar] [CrossRef]
- Kang, J.Y.; Bangoura, I.; Cho, J.Y.; Joo, J.; Choi, Y.S.; Hwang, D.S.; Hong, Y.K. Antifouling Effects of the Periostracum on Algal Spore Settlement in the Mussel Mytilus edulis. Fish. Aquat. Sci. 2016, 19, 7. [Google Scholar] [CrossRef]
- Radman, S.; Čižmek, L.; Babić, S.; Cikoš, A.M.; Čož-Rakovac, R.; Jokić, S.; Jerković, I. Bioprospecting of Less-Polar Fractions of Ericaria crinita and Ericaria amentacea: Developmental Toxicity and Antioxidant Activity. Mar. Drugs 2022, 20, 57. [Google Scholar] [CrossRef]
- Cho, J.-Y. Antifouling Activity of Giffinisterone B and Oleamide Isolated from a Filamentous Bacterium Leucothrix mucor Culture against Ulva pertusa. Korean J. Fish. Aquat. Sci. 2012, 45, 30–34. [Google Scholar] [CrossRef]
- Selvin, J.; Shanmughapriya, S.; Gandhimathi, R.; Seghal Kiran, G.; Rajeetha Ravji, T.; Natarajaseenivasan, K.; Hema, T.A. Optimization and Production of Novel Antimicrobial Agents from Sponge Associated Marine Actinomycetes Nocardiopsis dassonvillei MAD08. Appl. Microbiol. Biotechnol. 2009, 83, 435–445. [Google Scholar] [CrossRef]
- Hameed, I.H.; Altameme, H.J.; Mohammed, G.J. Evaluation of Antifungal and Antibacterial Activity and Analysis of Bioactive Phytochemical Compounds of Cinnamomum zeylanicum (Cinnamon Bark) Using Gas Chromatography-Mass Spectrometry. Orient. J. Chem. 2016, 32, 1769–1788. [Google Scholar] [CrossRef]
- Shao, J.; He, Y.; Li, F.; Zhang, H.; Chen, A.; Luo, S.; Gu, J.D. Growth Inhibition and Possible Mechanism of Oleamide against the Toxin-Producing Cyanobacterium Microcystis aeruginosa NIES-843. Ecotoxicology 2016, 25, 225–233. [Google Scholar] [CrossRef]
- Sherein, I.A.E.M.; Mohamed, A.A.; Ahmed, M.G.; Manal, F.A.A. In Vitro Antibacterial Activities of Dietary Medicinal Ethanolic Extracts against Pathogenic Reference Strains of Animal Origin. Afr. J. Microbiol. Res. 2013, 7, 5261–5270. [Google Scholar] [CrossRef]
- Niu, T.; Fu, G.; Zhou, J.; Han, H.; Chen, J.; Wu, W.; Chen, H. Floridoside Exhibits Antioxidant Properties by Activating HO-1 Expression via P38/ERK MAPK Pathway. Mar. Drugs 2020, 18, 105. [Google Scholar] [CrossRef] [PubMed]
- Courtois, A.; Simon-Colin, C.; Boisset, C.; Berthou, C.; Deslandes, E.; Guezennec, J.; Bordron, A. Floridoside Extracted from the Red Alga Mastocarpus stellatus Is a Potent Activator of the Classical Complement Pathway. Mar. Drugs 2008, 6, 407–417. [Google Scholar] [CrossRef] [PubMed]
- Kim, M.J.; Li, Y.X.; Dewapriya, P.; Ryu, B.; Kim, S.K. Floridoside Suppresses Pro-Inflammatory Responses by Blocking MAPK Signaling in Activated Microglia. BMB Rep. 2013, 46, 398–403. [Google Scholar] [CrossRef]
- Kang, H.K.; Seo, C.H.; Park, Y. The Effects of Marine Carbohydrates and Glycosylated Compounds on Human Health. Int. J. Mol. Sci. 2015, 16, 6018–6056. [Google Scholar] [CrossRef]
- Li, Y.X.; Li, Y.; Lee, S.H.; Qian, Z.J.I.; Kim, S.E.K. Inhibitors of Oxidation and Matrix Metalloproteinases, Floridoside, and D-Isofloridoside from Marine Red Alga Laurencia undulata. J. Agric. Food Chem. 2010, 58, 578–586. [Google Scholar] [CrossRef]
- Kulshreshtha, G.; Critchley, A.; Rathgeber, B.; Stratton, G.; Banskota, A.H.; Hafting, J.; Prithiviraj, B. Antimicrobial Effects of Selected, Cultivated Red Seaweeds and Their Components in Combination with Tetracycline, against Poultry Pathogen Salmonella enteritidis. J. Mar. Sci. Eng. 2020, 8, 511. [Google Scholar] [CrossRef]
- Liu, H.B.; Koh, K.P.; Kim, J.S.; Seo, Y.; Park, S. The Effects of Betonicine, Floridoside, and Isethionic Acid from the Red Alga Ahnfeltiopsis flabelliformis on Quorum-Sensing Activity. Biotechnol. Bioprocess. Eng. 2008, 13, 458–463. [Google Scholar] [CrossRef]
- Niwa, T.; Maeda, K.; Ohki, T.; Saito, A.; Sakakibara, J.; Kobayashi, K. Gas Chromatographic-Mass Spectrometric Identification of Isosaccharino-1,4-Lactone in Human Serum and Urine. Clin. Chem. 1980, 26, 1554–1561. [Google Scholar] [CrossRef]
- Rhimou, B. Antioxidant Activity of Rhodophyceae Extracts from Atlantic and Mediterranean Coasts of Morocco. Afr. J. Plant Sci. 2013, 7, 110–117. [Google Scholar] [CrossRef]
- Zubia, M.; Fabre, M.S.; Kerjean, V.; Deslandes, E. Antioxidant and Cytotoxic Activities of Some Red Algae (Rhodophyta) from Brittany Coasts (France). Bot. Mar. 2009, 52, 268–277. [Google Scholar] [CrossRef]
- Song, K.; Saini, R.K.; Keum, Y.S.; Sivanesan, I. Analysis of Lipophilic Antioxidants in the Leaves of Kaempferia parviflora Wall. Ex Baker Using LC–MRM–MS and GC–FID/MS. Antioxidants 2021, 10, 1573. [Google Scholar] [CrossRef]
- Chang, K.H.; Cheng, M.L.; Chiang, M.C.; Chen, C.M. Lipophilic Antioxidants in Neurodegenerative Diseases. Clin. Chim. Acta 2018, 485, 79–87. [Google Scholar] [CrossRef] [PubMed]
- Sohn, S.I.; Rathinapriya, P.; Balaji, S.; Balan, D.J.; Swetha, T.K.; Durgadevi, R.; Alagulakshmi, S.; Singaraj, P.; Pandian, S. Phytosterols in Seaweeds: An Overview on Biosynthesis to Biomedical Applications. Int. J. Mol. Sci. 2021, 22, 12691. [Google Scholar] [CrossRef]
- Pereira, H.; Barreira, L.; Figueiredo, F.; Custódio, L.; Vizetto-Duarte, C.; Polo, C.; Rešek, E.; Aschwin, E.; Varela, J. Polyunsaturated Fatty Acids of Marine Macroalgae: Potential for Nutritional and Pharmaceutical Applications. Mar. Drugs 2012, 10, 1920–1935. [Google Scholar] [CrossRef]
- Van Ginneken, V.J.T.; Helsper, J.P.F.G.; De Visser, W.; Van Keulen, H.; Brandenburg, W.A. Polyunsaturated Fatty Acids in Various Macroalgal Species from North Atlantic and Tropical Seas. Lipids Health Dis. 2011, 10, 104. [Google Scholar] [CrossRef]
- Jensen, A. Tocopherol Content of Seaweed and Seaweed Meal: I.—Analytical Methods and Distribution of Tocopherols in Benthic Algae. J. Sci. Food Agric. 1969, 20, 449–453. [Google Scholar] [CrossRef]
- Kumar, C.S.; Ganesan, P.; Suresh, P.V.; Bhaskar, N. Seaweeds as a Source of Nutritionally Beneficial Compounds—A Review. J. Food Sci. Technol. 2008, 45, 1–13. [Google Scholar]
- Jayasree, V.; Solimabi; Kamat, S.Y. Distribution of Tocopherol (Vitamin E) in Marine Algae from Goa, West Coast of India. Indian. J. Mar. Sci. 1985, 14, 228–229. [Google Scholar]
- Koizumi, J.; Takatani, N.; Kobayashi, N.; Mikami, K.; Miyashita, K.; Yamano, Y.; Wada, A.; Maoka, T.; Hosokawa, M. Carotenoid Profiling of a Red Seaweed Pyropia yezoensis: Insights into Biosynthetic Pathways in the Order Bangiales. Mar. Drugs 2018, 16, 426. [Google Scholar] [CrossRef]
- Gao, H.; Wang, Y.; Guo, Z.; Liu, Y.; Wu, Q.; Xiao, J. Optimization of Ultrasound-Assisted Extraction of Phenolics from Asparagopsis taxiformis with Deep Eutectic Solvent and Their Characterization by Ultra-High-Performance Liquid Chromatography-Mass Spectrometry. Front. Nutr. 2022, 9, 1036436. [Google Scholar] [CrossRef]
- Wang, J.; Jiang, X.; Mou, H.; Guan, H. Anti-Oxidation of Agar Oligosaccharides Produced by Agarase from a Marine Bacterium. J. Appl. Phycol. 2004, 16, 333–340. [Google Scholar] [CrossRef]
- Gómez-Ordóñez, E.; Jiménez-Escrig, A.; Rupérez, P. Bioactivity of Sulfated Polysaccharides from the Edible Red Seaweed Mastocarpus stellatus. Bioact. Carbohydr. Diet. Fibre 2014, 3, 29–40. [Google Scholar] [CrossRef]
- Carpena, M.; Garcia-Perez, P.; Garcia-Oliveira, P.; Chamorro, F.; Otero, P.; Lourenço-Lopes, C.; Cao, H.; Simal-Gandara, J.; Prieto, M.A. Biological Properties and Potential of Compounds Extracted from Red Seaweeds. Phytochem. Rev. 2023, 22, 1509–1540. [Google Scholar] [CrossRef] [PubMed]
- Amaro, H.M.; Pagels, F.; Tavares, T.G.; Costa, I.; Sousa-Pinto, I.; Guedes, A.C. Antioxidant and Anti-Inflammatory Potential of Seaweed Extracts as Functional Ingredients. Hydrobiology 2022, 1, 469–482. [Google Scholar] [CrossRef]
- Ryu, B.M.; Li, Y.X.; Kang, K.H.; Kim, S.K.; Kim, D.G. Floridoside from Laurencia undulata Promotes Osteogenic Differentiation in Murine Bone Marrow Mesenchymal Cells. J. Funct. Foods 2015, 19A, 505–511. [Google Scholar] [CrossRef]
- Januário, A.P.; Félix, R.; Félix, C.; Reboleira, J.; Valentão, P.; Lemos, M.F.L. Red Seaweed-Derived Compounds as a Potential New Approach for Acne Vulgaris Care. Pharmaceutics 2021, 13, 1930. [Google Scholar] [CrossRef]
- Januário, A.P.; Félix, C.; Félix, R.; Shiels, K.; Murray, P.; Valentão, P.; Lemos, M.F.L. Exploring the Therapeutical Potential of Asparagopsis armata Biomass: A Novel Approach for Acne Vulgaris Treatment. Mar. Drugs 2024, 22, 489. [Google Scholar] [CrossRef]
- Sanches-Fernandes, G.M.M.; Sá-Correia, I.; Costa, R. Vibriosis Outbreaks in Aquaculture: Addressing Environmental and Public Health Concerns and Preventive Therapies Using Gilthead Seabream Farming as a Model System. Front. Microbiol. 2022, 13, 904815. [Google Scholar] [CrossRef]
- Bansemir, A.; Blume, M.; Schröder, S.; Lindequist, U. Screening of Cultivated Seaweeds for Antibacterial Activity against Fish Pathogenic Bacteria. Aquaculture 2006, 252, 79–84. [Google Scholar] [CrossRef]
- Giuseppa, G.; Orazio, R.; Marina, M.; Domenico, A.; Giuseppe, C.; Caterina, F. Activity of Ethanolic Extracts of Asparagopsis taxiformis against the Major Molecular Types of Cryptococcus neoformans/C. gattii. Complex. Afr. J. Microbiol. Res. 2013, 7, 2662–2667. [Google Scholar] [CrossRef]
- Choi, J.-S.; Lee, B.-B.; Joo, C.-U.; Shin, S.-H.; Ha, Y.-M.; Bae, H.-J.; Choi, I.-S. Inhibitory Effects of Seaweed Extracts on Growth of Malassezia Furfur and Malassezia restricta. Fish. Aquat. Sci. 2009, 12, 29–34. [Google Scholar] [CrossRef]
- Perfect, J.R.; Cox, G.M. Drug Resistance in Cryptococcus neoformans. Drug Resist. Updates 1999, 2, 259–269. [Google Scholar] [CrossRef]
- Zafar, H.; Altamirano, S.; Ballou, E.R.; Nielsen, K. A Titanic Drug Resistance Threat in Cryptococcus neoformans. Curr. Opin. Microbiol. 2019, 52, 158–164. [Google Scholar] [CrossRef]
- Yang, F.; Jacobsen, S.; Jørgensen, H.J.L.; Collinge, D.B.; Svensson, B.; Finnie, C. Fusarium graminearum and Its Interactions with Cereal Heads: Studies in the Proteomics Era. Front. Plant Sci. 2013, 4, 37. [Google Scholar] [CrossRef]
- Ji, F.; He, D.; Olaniran, A.O.; Mokoena, M.P.; Xu, J.; Shi, J. Occurrence, Toxicity, Production and Detection of Fusarium mycotoxin: A Review. Food Prod. Process. Nutr. 2019, 1, 6. [Google Scholar] [CrossRef]
- Kazan, K.; Gardiner, D.M. Transcriptomics of Cereal–Fusarium graminearum Interactions: What We Have Learned so Far. Mol. Plant Pathol. 2018, 19, 764–778. [Google Scholar] [CrossRef]
- Chen, Y.; Kistler, H.C.; Ma, Z. Fusarium graminearum Trichothecene Mycotoxins: Biosynthesis, Regulation, and Management. Annu. Rev. Phytopathol. 2019, 57, 15–39. [Google Scholar] [CrossRef]
- Bai, G.; Shaner, G. Management and Resistance in Wheat and Barley to Fusarium Head Blight. Annu. Rev. Phytopathol. 2004, 42, 135–161. [Google Scholar] [CrossRef] [PubMed]
- De Wolf, E.D.; Madden, L.V.; Lipps, P.E. Risk Assessment Models for Wheat Fusarium Head Blight Epidemics Based on within-Season Weather Data. Phytopathology 2003, 93, 428–435. [Google Scholar] [CrossRef] [PubMed]
- Cambaza, E. Comprehensive Description of Fusarium graminearum Pigments and Related Compounds. Foods 2018, 7, 165. [Google Scholar] [CrossRef] [PubMed]
- Salvador, N.; Gómez Garreta, A.; Lavelli, L.; Ribera, M.A. Antimicrobial Activity of Iberian Macroalgae. Sci. Mar. 2007, 71, 101–113. [Google Scholar] [CrossRef]
- Hornsey, S.; Hide, D. The Production of Antimicrobial Compounds by British Marine Algae i. Antibiotic-Producing Marine Algae. Br. Phycol. J. 1974, 9, 353–361. [Google Scholar] [CrossRef]
- Oumaskour, K.; Boujaber, N.; Etahiri, S.; Assobhei, O. Anti-Inflammatory and Antimicrobial Activities of Twenty-Tree Marine Red Algae from the Coast of Sidi Bouzid (El Jadida-Morocco). Int. J. Pharm. Pharm. Sci. 2013, 5, 145–149. [Google Scholar]
- Swiecicka, I. Natural Occurrence of Bacillus thuringiensis and Bacillus cereus in Eukaryotic Organisms: A Case for Symbiosis. Biocontrol Sci. Technol. 2008, 18, 221–239. [Google Scholar] [CrossRef]
- Naclerio, G.; Ricca, E.; Sacco, M.; De Felice, M. Antimicrobial Activity of a Newly Identified Bacteriocin of Bacillus cereus. Appl. Env. Microbiol. 1993, 59, 4313–4316. [Google Scholar] [CrossRef]
- Vilà, B.; Fontgibell, A.; Badiola, I.; Esteve-Garcia, E.; Jiménez, G.; Castillo, M.; Brufau, J. Reduction of Salmonella enterica Var. Enteritidis Colonization and Invasion by Bacillus cereus Var. Toyoi Inclusion in Poultry Feeds. Poult. Sci. 2009, 88, 975–979. [Google Scholar] [CrossRef]
- FEEDAP. Safety and Efficacy of the Product Toyocerin® (Bacillus cereus Var. Toyoi) as Feed Additive for Rabbit Breeding Does—Scientific Opinion of the Panel on Additives and Products or Substances Used in Animal Feed. EFSA J. 2009, 913, 1–13. [Google Scholar] [CrossRef]
- FEEDAP. Opinion of the Panel on Additives and Products or Substances Used in Animal Feed (FEEDAP) on the Safety and Efficacy of the Product Toyocerin® (Bacillus cereus Var. Toyoi) as a Feed Additive for Sows from Service to Weaning, in Accordance with Regulation. EFSA J. 2007, 458, 1–9. [Google Scholar] [CrossRef]
- Banerjee, G.; Gorthi, S.; Chattopadhyay, P. Beneficial Effects of Bio-Controlling Agent Bacillus cereus IB311 on the Agricultural Crop Production and Its Biomass Optimization through Response Surface Methodology. Acad. Bras. Cienc. 2018, 90, 2149–2159. [Google Scholar] [CrossRef]
- Figueroa-López, A.M.; Cordero-Ramírez, J.D.; Martínez-Álvarez, J.C.; López-Meyer, M.; Lizárraga-Sánchez, G.J.; Félix-Gastélum, R.; Castro-Martínez, C.; Maldonado-Mendoza, I.E. Rhizospheric Bacteria of Maize with Potential for Biocontrol of Fusarium verticillioides. Springerplus 2016, 5, 330. [Google Scholar] [CrossRef] [PubMed]
- Hapsoh; Dini, I.R.; Wawan; Wulandari, M. Application of Bacillus cereus Biofertilizer Formulation of Soybean (Glycine max L. Merril) Growth and Yield Support Sustainable Agriculture on Peatlands. IOP Conf. Ser. Earth Environ. Sci. 2022, 977, 12022. [Google Scholar] [CrossRef]
- Cardoso, A.F.; Alves, E.C.; da Costa, S.D.A.; de Moraes, A.J.G.; da Silva Júnior, D.D.; Lins, P.M.P.; da Silva, G.B. Bacillus cereus Improves Performance of Brazilian Green Dwarf Coconut Palms Seedlings with Reduced Chemical Fertilization. Front. Plant Sci. 2021, 12, 649487. [Google Scholar] [CrossRef] [PubMed]
- Guegan, H.; Prat, E.; Robert-Gangneux, F.; Gangneux, J.-P. Azole Resistance in Aspergillus fumigatus: A Five-Year Follow up Experience in a Tertiary Hospital with a Special Focus on Cystic Fibrosis. Front. Cell Infect. Microbiol. 2021, 10, 613774. [Google Scholar] [CrossRef]
- Rogawansamy, S.; Gaskin, S.; Taylor, M.; Pisaniello, D. An Evaluation of Antifungal Agents for the Treatment of Fungal Contamination in Indoor Air Environments. Int. J. Environ. Res. Public Health 2015, 12, 6319–6332. [Google Scholar] [CrossRef]
- Türk, H.; Yilmaz, M.; Tay, T.; Türk, A.Ö.; Kivanç, M. Antimicrobial Activity of Extracts of Chemical Races of the Lichen Pseudevernia furfuracea and Their Physodic Acid, Chloroatranorin, Atranorin, and Olivetoric Acid Constituents. Z. Fur Naturforschung Sect. C J. Biosci. 2006, 61, 499–507. [Google Scholar] [CrossRef]
- Blechert, O.; Zheng, H.; Zang, X.; Wang, Q.; Liu, W. Influence of the Cultivation Medium and PH on the Pigmentation of Trichophyton rubrum. PLoS ONE 2019, 14, e0222333. [Google Scholar] [CrossRef]
- Passos, F.R.S.; Araújo-Filho, H.G.; Monteiro, B.S.; Shanmugam, S.; Araújo, A.A.d.S.; Almeida, J.R.G.d.S.; Thangaraj, P.; Júnior, L.J.Q.; Quintans, J.d.S.S. Anti-Inflammatory and Modulatory Effects of Steroidal Saponins and Sapogenins on Cytokines: A Review of Pre-Clinical Research. Phytomedicine 2022, 96, 153842. [Google Scholar] [CrossRef]
- Aziz, E.; Batool, R.; Khan, M.U.; Rauf, A.; Akhtar, W.; Heydari, M.; Rehman, S.; Shahzad, T.; Malik, A.; Mosavat, S.H.; et al. An Overview on Red Algae Bioactive Compounds and Their Pharmaceutical Applications. J. Complement. Integr. Med. 2021, 17. [Google Scholar] [CrossRef]
- Araújo, A.M.; Bastos, M.d.L.; Fernandes, E.; Carvalho, F.; Carvalho, M.; Guedes de Pinho, P. GC–MS Metabolomics Reveals Disturbed Metabolic Pathways in Primary Mouse Hepatocytes Exposed to Subtoxic Levels of 3,4-Methylenedioxymethamphetamine (MDMA). Arch. Toxicol. 2018, 92, 3307–3323. [Google Scholar] [CrossRef]
- Félix, C.; Félix, R.; Carmona, A.M.; Januário, A.P.; Dias, P.D.M.; Vicente, T.F.L.; Silva, J.; Alves, C.; Pedrosa, R.; Novais, S.C.; et al. Cosmeceutical Potential of Grateloupia turuturu: Using Low-Cost Extraction Methodologies to Obtain Added-Value Extracts. Appl. Sci. 2021, 11, 1650. [Google Scholar] [CrossRef]
- Dávalos, A.; Gómez-Cordovés, C.; Bartolomé, B. Extending Applicability of the Oxygen Radical Absorbance Capacity (ORAC-Fluorescein) Assay. J. Agric. Food Chem. 2004, 52, 48–54. [Google Scholar] [CrossRef] [PubMed]
- Reboleira, J.; Félix, R.; Vicente, T.F.L.; Januário, A.P.; Félix, C.; de Melo, M.M.R.; Silva, C.M.; Ribeiro, A.C.; Saraiva, J.A.; Bandarra, N.M.; et al. Uncovering the Bioactivity of Aurantiochytrium Sp.: A Comparison of Extraction Methodologies. Mar. Biotechnol. 2022, 24, 40–54. [Google Scholar] [CrossRef] [PubMed]
- Clinical and Laboratory Standards Institute. M07-A10: Methods for Dilution Antimicrobial Susceptibility Tests for Bacteria That Grow Aerobically; Clinical and Laboratory Standards Institute: Wayne, PA, USA, 2015. [Google Scholar]
- Clinical and Laboratory Standards Institute. Performance Standards for Antimicrobial Susceptibility Testing CLSI Supplement M100S; Clinical and Laboratory Standards Institute: Wayne, PA, USA, 2016. [Google Scholar]
- Clinical and Laboratory Standards Institute. Performance Standards for Antifungal Susceptibility Testing of Yeasts, 1st ed.; Clinical and Laboratory Standards Institute: Wayne, PA, USA, 2017. [Google Scholar]
- Vicente, T.F.L.; Lemos, M.F.L.; Félix, R.; Valentão, P.; Félix, C. Marine Macroalgae, a Source of Natural Inhibitors of Fungal Phytopathogens. J. Fungi 2021, 7, 1006. [Google Scholar] [CrossRef]
- Grover, R.K.; Moore, J.-D. Toxicometric Studies of Fungicides against Brown Rot Organisms Sclerotinia fructicola and S. laxa. Phytopathology 1962, 52, 876–879. [Google Scholar]
- Repetto, G.; del Peso, A.; Zurita, J.L. Neutral Red Uptake Assay for the Estimation of Cell Viability/Cytotoxicity. Nat. Protoc. 2008, 3, 1125–1131. [Google Scholar] [CrossRef]
- Benevides Bahiense, J.; Marques, F.M.; Figueira, M.M.; Vargas, T.S.; Kondratyuk, T.P.; Endringer, D.C.; Scherer, R.; Fronza, M. Potential Anti-Inflammatory, Antioxidant and Antimicrobial Activities of Sambucus australis. Pharm. Biol. 2017, 55, 991–997. [Google Scholar] [CrossRef]

| Rt | Relative Abundance (%) | Exp. Kovats | Compound Names | Lit. Kovats | Identification Level |
|---|---|---|---|---|---|
| 8.37 | 34.33 | Glycerol (3TMS) | L1 | ||
| 11.60 | 0.70 | 1695 | LMWCD | n.a. | L3 |
| 11.66 | 0.52 | 1702 | LMWCD | n.a. | L3 |
| 11.76 | 0.47 | 1714 | LMWCD | n.a. | L3 |
| 11.83 | 0.38 | 1721 | LMWCD | n.a. | L3 |
| 11.96 | 1.93 | 1736 | Isosaccharino-1,4-lactone (3TMS) isomer 1 | n.av. | L2 |
| 12.05 | 6.84 | 1747 | Isosaccharino-1,4-lactone (3TMS) isomer 2 | n.av. | L2 |
| 13.38 | 0.57 | 1901 | LMWCD | n.a. | L3 |
| 13.62 | 0.57 | 1930 | LMWCD | n.a. | L3 |
| 13.90 | 0.63 | 1961 | LMWCD | n.a. | L3 |
| 14.48 | 0.83 | Palmitic acid (TMS) | L1 | ||
| 15.53 | 0.91 | 2150 | LMWCD | n.a. | L3 |
| 15.86 | 42.93 | 2189 | Floridoside (6TMS) | 2180 | L2 |
| 16.17 | 0.98 | 2225 | LMWCD | n.a. | L3 |
| 16.28 | 1.06 | 2238 | LMWCD | n.a. | L3 |
| 16.57 | 1.13 | 2272 | LMWCD | n.a. | L3 |
| 17.32 | 5.22 | Oleamide | L1 |
| Assay | Antioxidant Activity (Mean ± SEM) |
|---|---|
| FRAP (mM eq. Fe2+/mg extract) | 1.96 ± 0.17 |
| ORAC (µmol eq. Trolox/g extract) | 15.75 ± 1.34 |
| LPIP (% inhibition at 1 mg extract/mL) | 11.5 ± 8.9 |
| Species | GRSDF (Mean [95CI], in µm·h−1, and % Inhibition) | Control Growth Rate (Mean [95CI], in µm·h−1) |
|---|---|---|
| A. fumigatus | 27.71 [23.56; 31.86] (19.5%) | 142.2 [138.8; 145.7] |
| F. graminearum | 66.92 [55.94; 77.9] (40%) | 167.3 [163.8; 170.7] |
| S. vesicarium | 19.77 [16.12; 23.42] (19.6%) | 100.9 [98.51; 103.2] |
| T. rubrum | −1.57 [−2.32; −0.83] (g.s.) | 34.91 [34.37; 35.45] |
| Species | Normal Phenotype | Phenotypic Alterations |
|---|---|---|
| A. fumigatus | White mycelium, with a centered dark pigmentation ring (spores) [Figure 3a] | Inhibition of sporulation at 1–2 mg/mL [Figure 3b] |
| F. graminearum | Dark orange mycelium, with yellow borders; yellow aerial hyphae at center (plug) [see Figure 4a] | Marked reduction of pigmentation, attributable to extract (1–2 mg/mL); also, weakened mycelium and absent aerial hyphae, but attributable to vehicle (DMSO). [see Figure 4b–d] |
| S. vesicarium | Top view: white mycelium and aerial hyphae; Bottom view: dark pigmentation concentric ring in mycelium [see Figure 5a,b] | Partial inhibition of pigmentation at 1.5–2 mg/mL [see Figure 5c] |
| T. rubrum | Top view: white mycelium and aerial hyphae; Bottom view: orange pigmentation concentric ring in mycelium [see Figure 6a,b] | 1–2 mg/mL: Inhibition of bottom orange pigmentation and stimulation of top pinkish pigmentation [see Figure 6c] |
| Species | Before Assay | During Assay | |||
|---|---|---|---|---|---|
| CM | gT&T | CM | gT&T | AA | |
| Bacillus cereus | TSA | 24 h; 35 °C | MHB II | 20 h; 35 °C | CIP 4 µg/mL |
| Staphylococcus aureus | TSYEA | 24 h; 35 °C | MHB II | 20 h; 35 °C | TET 16 µg/mL |
| Staphylococcus epidermidis | TSYEA | 24 h; 35 °C | MHB II | 20 h; 35 °C | TET 16 µg/mL |
| Escherichia coli | TSA | 24 h; 35 °C | MHB II | 20 h; 35 °C | CIP 4 µg/mL |
| Cutibacterium acnes | CBA | 72 h a; 35 °C | BHI b | 48 h a; 35 °C | VAN 4 µg/mL |
| Vibrio parahaemolyticus | TSA c | 24 h; 35 °C | MHB II c | 20 h; 35 °C | CTX 4 µg/mL |
| Streptococcus uberis | CBA | 24 h d; 35 °C | BHI b | 20 h d; 35 °C | CIP 4 µg/mL |
| Candida albicans | PDA | 24 h; 35 °C | RPMI | 48 h; 35 °C | AMB 4 µg/mL |
| Cryptococcus neoformans | PDA | 48 h; 25 °C | RPMI | 72 h; 35 °C | AMB 4 µg/mL |
| Malassezia furfur | PDA e | 72 h; 30 °C | SDB f | 72 h; 35 °C | AMB 4 µg/mL |
Disclaimer/Publisher’s Note: The statements, opinions and data contained in all publications are solely those of the individual author(s) and contributor(s) and not of MDPI and/or the editor(s). MDPI and/or the editor(s) disclaim responsibility for any injury to people or property resulting from any ideas, methods, instructions or products referred to in the content. |
© 2025 by the authors. Licensee MDPI, Basel, Switzerland. This article is an open access article distributed under the terms and conditions of the Creative Commons Attribution (CC BY) license (https://creativecommons.org/licenses/by/4.0/).
Share and Cite
Félix, R.; Dias, P.; Januário, A.P.; Félix, C.; Blanco, A.; Amaro, F.; Guedes de Pinho, P.; Valentão, P.; Lemos, M.F.L. On the Antimicrobial Potential of Asparagopsis armata’s Ethanol Extract: A New Multiple-Industry Bio-Product? Int. J. Mol. Sci. 2025, 26, 11358. https://doi.org/10.3390/ijms262311358
Félix R, Dias P, Januário AP, Félix C, Blanco A, Amaro F, Guedes de Pinho P, Valentão P, Lemos MFL. On the Antimicrobial Potential of Asparagopsis armata’s Ethanol Extract: A New Multiple-Industry Bio-Product? International Journal of Molecular Sciences. 2025; 26(23):11358. https://doi.org/10.3390/ijms262311358
Chicago/Turabian StyleFélix, Rafael, Pedro Dias, Adriana P. Januário, Carina Félix, Andreu Blanco, Filipa Amaro, Paula Guedes de Pinho, Patrícia Valentão, and Marco F. L. Lemos. 2025. "On the Antimicrobial Potential of Asparagopsis armata’s Ethanol Extract: A New Multiple-Industry Bio-Product?" International Journal of Molecular Sciences 26, no. 23: 11358. https://doi.org/10.3390/ijms262311358
APA StyleFélix, R., Dias, P., Januário, A. P., Félix, C., Blanco, A., Amaro, F., Guedes de Pinho, P., Valentão, P., & Lemos, M. F. L. (2025). On the Antimicrobial Potential of Asparagopsis armata’s Ethanol Extract: A New Multiple-Industry Bio-Product? International Journal of Molecular Sciences, 26(23), 11358. https://doi.org/10.3390/ijms262311358

